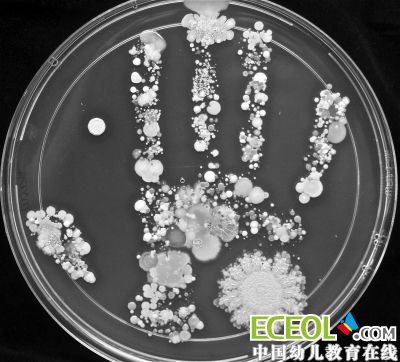
孩子不爱洗手怎么办 "学霸妈妈"一招治服

孩子不爱洗手怎么办?很多中国妈妈总会跟在子女们的身后唠叨,不过,近日美国一位妈妈的做法令人耳目一新。她让自己8岁半的儿子在玩耍后,将自己的脏手盖在培养皿上进行细菌培养,竟然得到了一个由各种细菌组成的细菌手印。这张照片在微博上热传,引发无数网友热议,由手上细菌、真菌等经过培养后组成的手印让不少网友看过之后表示:“回家赶紧洗洗手吧。”
手印的制作者名叫Tasha Sturm,是美国卡布利洛学院(Cabrillo College)实验室的技术人员,这个手印来自她8岁半大的儿子。在国外一个关于微生物的网站上,刊登了这张原始图片。
Tasha描述,培养皿直径为15厘米,在对手上的菌落进行培养前,儿子曾经在室外玩耍,之后便在培养皿的培养基上盖了个手印。不过这个手印却并没有按照常规的培养方法,而是经过了一段时间的培养。
Tasha先是将盖有儿子手印的培养皿放进温度在37摄氏度的恒温箱里培养了24-48小时,这时候手上常见的金黄色葡萄球菌、微球菌开始生长。
然后,她又将培养皿放在室温为22摄氏度的室内待了3天以上,而此时培养基上黏附的酵母菌或真菌开始形成红色或粉色甚至黄色的菌落。
乍一看,手印的颜色十分漂亮,有白色的,也有黄色的,还有淡红色的。
在Tasha的介绍里,她并没有明确说出手上培养出来的都是什么菌。不过不少有着生物学背景的网友看过之后,对手印里的细菌菌落进行了猜测——
大拇指和中指顶端是芽孢杆菌,食指下部那些白色正圆的菌落是金黄色葡萄球菌,旁边圆圆的菌落疑似酵母菌,中指下部和无名指中部是微球菌,手掌里还有青霉、沙雷氏菌、真菌等。
对于Tasha用这种方式告诫孩子和学生要洗手的做法,不少网友们戏称:“学霸妈妈的教育不需要语言,看完后马上去洗了十次手。”
具备一定专业知识的网友们表示,其实人体皮肤表面有很多细菌,但大部分都没有什么危害。但值得注意的是,一些传染性致病性强的细菌也可以通过人体皮肤的接触来传播,因此勤洗手还是很有必要的!
2015-12-07
2015-12-07
2015-12-07
2015-12-07
2015-12-07
2015-12-07